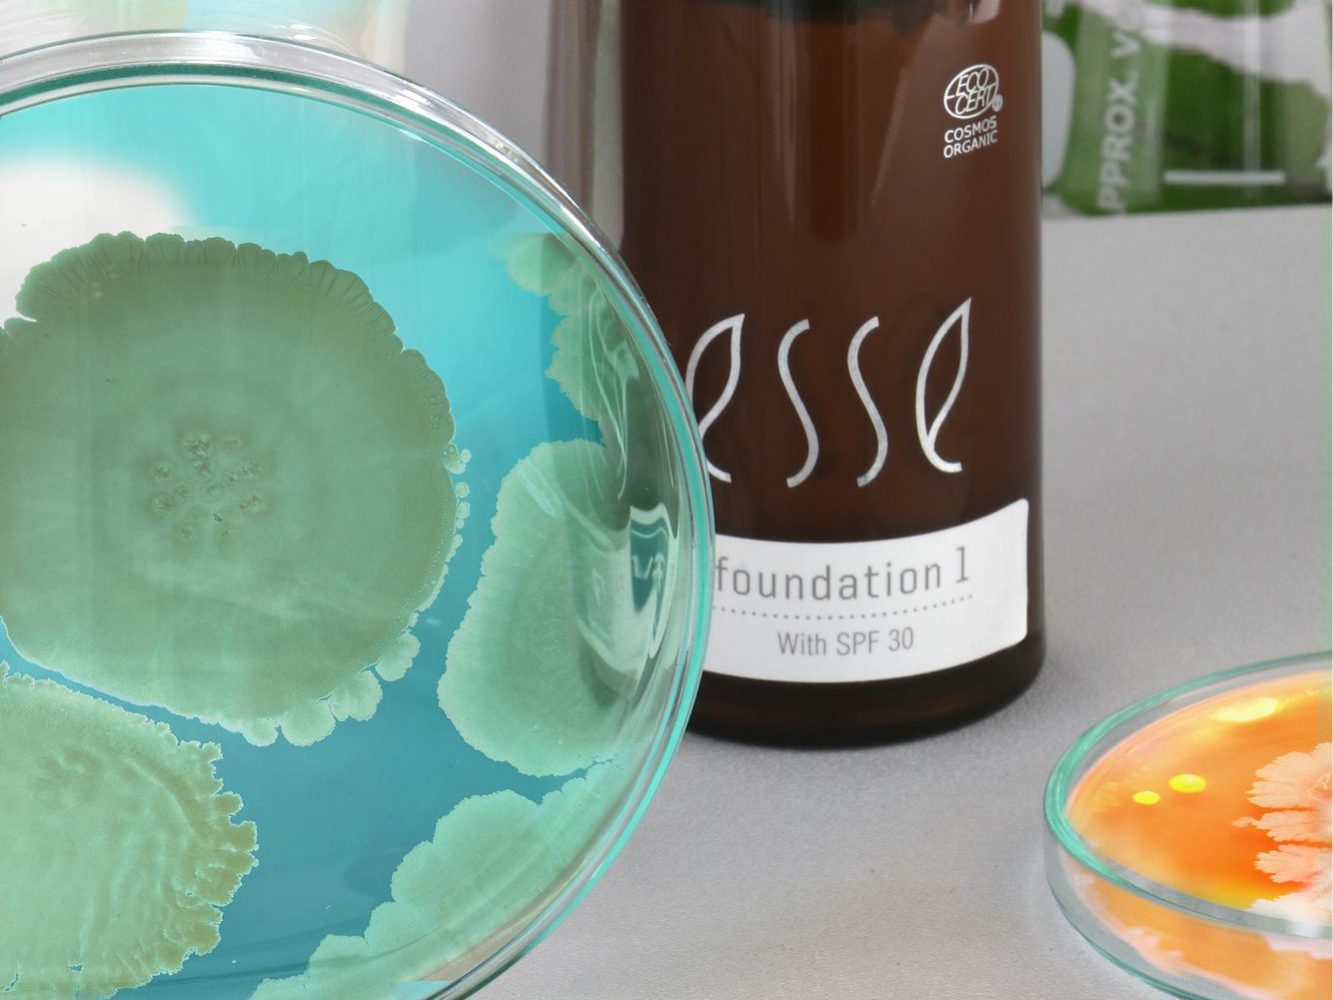

This organic, microbiome-friendly foundation provides medium coverage and is available in ten shades. Below are just some of the benefits you can expect.
Layer to achieve light to medium coverage with a natural, illuminating finish. The lightweight formulation leaves the skin looking sheer and radiant whilst moisturising and strengthening barrier function.
Boost your skin’s microbiome with pre and probiotic ingredients. Proven to strengthen barrier function and contribute to a healthy skin microbiome, the foundation will not pollute the skin with harmful ingredients often associated with colour cosmetics.
We’ve got you covered in more than one way. With SPF 30 and a range of anti-oxidants this is the most natural way to get protection from the sun, from environmental aggressors and lifestyle pollutants.
Foundation doesn’t get more natural than this – certified to COSMOS organic standards by Ecocert means you are not polluting your skin with harmful toxins that have both an impact on your skin and your body.
Accredited vegan and cruelty free because we care as much as you.
Fragrance free and loaded with skin strengthening probiotics, this is the all-round best foundation to calm and protect and strengthen sensitive skins.
The key to a beautifully natural foundation is a perfect colour match, with 10 shade to choose from, there is a perfect match for every skin tone.